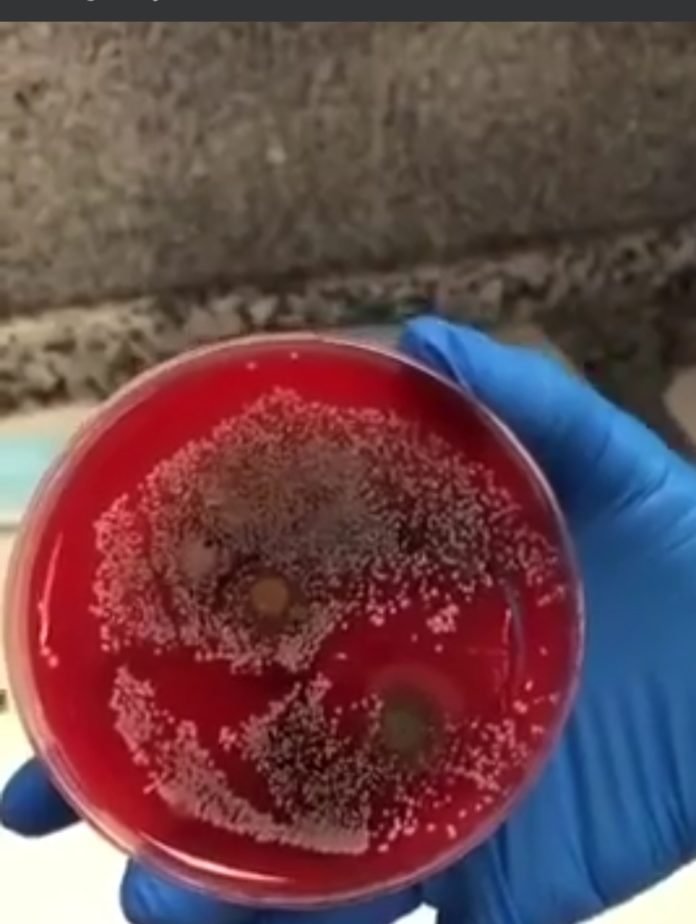

Dok ljudi nisu nosili maske bilo je manje ” zaraženih”, udišući svoje otrove i bakterije na velikim vrućinama ljudi se razboljevaju.
U rujnu sve strpajte u pritvor dok psihički ne puknu, jer tako se brine o zdravlju ljudi. To je osnova svakog zdrastvenog sustava.
Od čega će ljudi živjeti, ako ne rade , nije nikoga briga. Evo nekih idiotskih naslova u vezi zastrašivanje koronom:

Ispitivanje uzoraka maski u laboratoriji: 1 od platna, ručno rađene- hrpa streptokoka, smeđe zarazne točke i još neke neidentificirane bakterije.

2- koju je nosila istraživačica u torbi za super market, samo par puta je koristila na sat vremena, uvijek je bila zatvorena – Ima male stafilokoke

3- nova maska, nekorištena- ima nekoliko zaraznih bakterija vjerovatno pri vađenju iz kutije
4- koju je nosila u trenutku uzimanja uzorka, i koristila je 2 puta na kratko- ima streptokoke, stafilokoke i neidentificirane bakterije.

Ispitivanje uzoraka maski u laboratoriju:
5 – koristi se 3 tjedna, 8 sati dnevno i više svaki dan – užas, ima bakterije, viruse, patogene elemente i tko zna što, izdvojila je za detaljniju analizu. Savjet: ako moramo ponovo nositi istu masku da je poškropimo nekim dezinfekcijskim sredstvom, osušimo je i ponovno upotrijebimo. Njegov lijek je više na biljnoj osnovi …

5 – koristi se 3 tjedna, 8 sati dnevno i više svaki dan – užas, ima bakterije, viruse, patogene elemente i tko zna što, izdvojila je za detaljniju analizu. Savjet: ako moramo ponovo nositi istu masku da je poškropimo nekim dezinfekcijskim sredstvom, osušimo je i ponovno upotrijebimo. Njegov lijek je više na biljnoj osnovi …

Ako ne nosite maske psihopate u policiji vas zlostavljaju, guše i tako se brinu o vašem zdravlju.

Huška se ljude na gladne ljude, brani im se hrana, jedan čovjek kod nas napravo samoubojstvo.

VEZANI ČLANAK